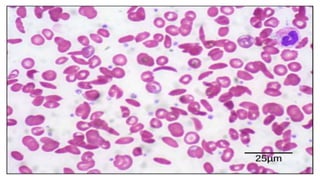

Este documento describe las proteínas, incluyendo su definición como moléculas formadas por aminoácidos unidos por enlaces peptídicos, su clasificación en proteínas simples y conjugadas, y sus estructuras primaria, secundaria, terciaria y cuaternaria. También explica cómo las proteínas pueden desnaturalizarse por cambios en el pH o la temperatura, perdiendo su forma tridimensional funcional.